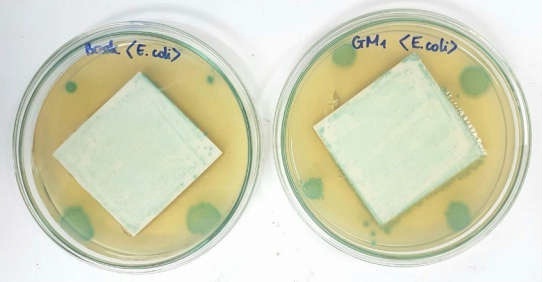

Công nghệ tổng hợp vật liệu kháng khuẩn mới
Đây là kết quả của đề tài “Nghiên cứu tổng hợp vật liệu nano kháng khuẩn trên cơ sở kết hợp ZnO và TiO2 hướng đến ứng dụng trên gạch men và PVC”, được Sở Khoa học và Công nghệ TP.HCM nghiệm thu năm 2018.
PGS.TS Huỳnh Kỳ Phương Hạ (chủ nhiệm đề tài) cho biết, hiện vấn đề ô nhiễm môi trường sinh thái do các hoạt động sản xuất và sinh hoạt gây ra ngày càng nghiêm trọng, khiến sức khỏe con người chịu nhiều nguy hiểm do các loại bệnh tật, vi khuẩn, virus có hại (thậm chí là các chủng vi khuẩn biến dị). Vì vậy, gần đây đã có nhiều nghiên cứu tổng hợp các loại vật liệu có khả năng kháng khuẩn cao, nhằm đẩy lùi bệnh tật và dịch bệnh, nâng cao chất lượng sống.
Trong đó, việc tổng hợp các vật liệu nano oxide kim loại, tiêu biểu như titanium dioxide (TiO2) và zinc oxide (ZnO) có vai trò quan trọng, nhất là trong lĩnh vực kháng khuẩn. Các kết quả công bố cho thấy, nano ZnO có khả năng kháng khuẩn ngay cả khi không có mặt ánh sáng mặt trời. Tuy nhiên, hoạt tính kháng khuẩn của nó lại suy giảm dần theo thời gian. Ngoài ra, mỗi loại nano oxide lại tồn tại một vài yếu điểm riêng. Do vậy, cần nghiên cứu khả năng kết hợp nhiều loại nano oxide với nhau để tạo ra loại vật liệu có tính năng ưu việt.
Với đề tài này, nhóm tác giả tập trung nghiên cứu công nghệ tổng hợp các loại vật liệu trên cơ sở ZnO/TiO2 kết hợp bổ sung Ag (bạc) kim loại để kháng khuẩn. Việc tổng hợp loại vật liệu này và ứng dụng của chúng chưa được nghiên cứu nhiều trên thế giới, và chưa từng được công bố trong nước.
Kết quả, các nhà nghiên cứu đã chế tạo thành công các vật liệu ZnO, ZnTiO3, Zn2TiO4, và các vật liệu mới là Ag/ZnTiO3 có cấu trúc peroskite, Ag/Zn2TiO4 có cấu trúc spinel với kích thước nanomet bằng phương pháp phức chất trung gian trên cơ sở phương pháp sol-gel. Các vật liệu tổng hợp được có tính kháng khuẩn trong môi trường nước, khi được phủ lên gạch men và bề mặt nhựa, cho phép sản xuất ra loại gạch men và nhựa kháng khuẩn, dùng trong các lĩnh vực y tế và gia dụng.
Các nhà nghiên cứu cũng khảo sát điều kiện tổng hợp vật liệu cấu trúc spinel Zn2TiO4 và cấu trúc perovskite ZnTiO3, sau đó đưa Ag kim loại vào và khảo sát tính kháng khuẩn của các loại vật liệu này. Cụ thể, các thông số vật lý của vật liệu và ảnh hưởng của các yếu tố như tỷ lệ giữa tiền chất và chất tạo phức EDTA (ethylenediaminetetraacetic acid) đến khả năng tạo thành vật liệu có cấu trúc peroskite hay vật liệu có cấu trúc spinel. Đây là một trong những đóng góp mới của đề tài vì đến nay chưa có công trình nào nghiên cứu tổng hợp các vật liệu Ag/ZnTiO3 có cấu trúc peroskite và Ag/Zn2TiO4 có cấu trúc spinel với kích thước nanomet, được tạo thành khi thay đổi tỷ lệ giữa tiền chất Zn2+ và tác nhân tạo phức EDTA.
Khảo sát ảnh hưởng của pH đến kích thước tinh thể của vật liệu cho thấy, có thể thực hiện quá trình tổng hợp vật liệu (cả hai dạng) trong khoảng pH rất rộng (từ 4,5±0,5 đến 8,5±0,5) mà không ảnh hưởng đáng kể đến tính chất vật liệu.
Về ảnh hưởng của nhiệt độ nung và thời gian nung đến cấu trúc vật liệu, các nhà nghiên cứu đã xác định nhiệt độ nung thích hợp nhất là 6500C (thời gian nung là 2 giờ) đối với quá trình tổng hợp Ag/ZnTiO3 và 1 giờ đối với Ag/Zn2TiO4. Ảnh hưởng của lượng Ag nano được thêm vào vật liệu có cấu trúc peroskite và vật liệu có cấu trúc spinel cũng được khảo sát. Kết quả cho thấy, khi thêm Ag không làm ảnh hưởng đáng kể đến kích thước của vật liệu. Vật liệu được dope thêm Ag có tính kháng khuẩn cao hơn so với vật liệu ZnTiO3 và Zn2TiO4 nguyên chất.
Sau khi tổng hợp, các vật liệu Ag/ZnTiO3 và Ag/Zn2TiO4 đều có tính kháng khuẩn tốt khi có ánh sáng mặt trời và vẫn có tính kháng khuẩn khá tốt khi không có ánh sáng mặt trời. Kết quả kháng khuẩn của gạch men sau khi đưa vật liệu lên bề mặt bằng phương pháp đưa trực tiếp vào men cho thấy, các mẫu gạch có tính kháng khuẩn với hàm lượng từ 2g/m2 với vật liệu Ag/Zn2TiO4 và từ 5g/m2 với vật liệu Ag/ZnTiO3. Kết quả kháng khuẩn của mẫu nhựa PVC sau khi đưa vật liệu lên bề mặt cho thấy, mẫu có tính kháng khuẩn với hàm lượng từ 4g/m2 vật liệu Ag/Zn2TiO4 trên bề mặt nhựa.
Tiềm năng ứng dụng
Theo PGS. TS Huỳnh Kỳ Phương Hạ, đề tài đã đưa ra được công nghệ tổng hợp vật liệu kháng khuẩn Ag/ZnTiO3 và Ag/Zn2TiO4 bằng phương pháp phức chất trung gian. Điểm khác biệt chủ yếu là sản phẩm trung gian là phức chất hữu cơ – kim loại, trong khi phương pháp sol-gel không tạo phức mà tạo thành hydroxide kim loại. Phương pháp này cho thấy nhiều ưu điểm như đơn giản, dễ thực hiện, dễ tạo thành sản phẩm có kích thước nanomet; sản phẩm đạt độ đồng nhất và độ tinh khiết cao; tiền chất ban đầu có giá thành rẻ hơn các phương pháp khác; thiết bị đơn giản, dễ tiến hành thực hiện với quy mô công nghiệp. Do vậy, công nghệ này có tiềm năng ứng dụng lớn, cho phép sản xuất lượng sản phẩm đủ để ứng dụng vào thực tế, khi đưa lên gạch men và bề mặt nhựa PVC để sản xuất các sản phẩm có tính kháng khuẩn trong y tế và dân dụng. Công nghệ không đòi hỏi đầu tư quá cao, hoàn toàn có thể thực hiện được trong nước với các vật liệu có hiệu quả kháng khuẩn tốt.
Tuy nhiên, để triển khai ứng dụng, đề tài cần tiếp tục (quy mô pilot) sản xuất thử nghiệm một lượng gạch men và nhựa PVC phủ lớp vật liệu kháng khuẩn và sử dụng trong thực tế để đánh giá khả năng tương thích, cụ thể cho các cơ sở y tế và hộ dân cư ở những nơi có nguồn nước bị nhiễm vi sinh vật.
Điểm còn bất cập của việc đưa vật liệu kháng khuẩn lên gạch men hay men sứ là hoạt tính kháng khuẩn sẽ mất dần theo thời gian, khiến hiệu quả kinh tế của sản phẩm không cao, do không thể tráng lại lớp men để đưa chất kháng khuẩn vào mà phải thay luôn (hoặc chỉ sử dụng như sản phẩm thông thường). Vì vậy, hiện nhóm tác giả đang tiếp tục nghiên cứu ứng dụng trong vecni trên gỗ. Với sản phẩm này, khi hết hoạt tính kháng khuẩn thì chỉ cần sơn lại vecni bề mặt. Công việc này khá thuận lợi do cũng giống như đánh vecni lại. Khi đó, sản phẩm hoàn toàn có thể triển khai ứng dụng rộng rãi, mang lại hiệu quả kinh tế cao.
Vân Nguyễn (CESTI)